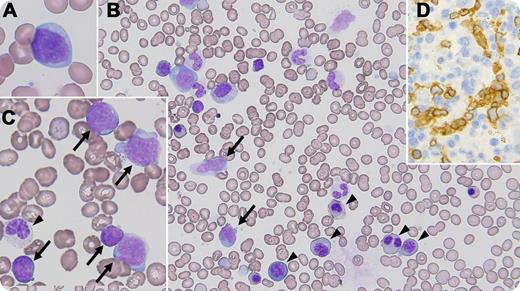
A previously healthy 23-year-old Japanese male had complained of a fever lasting a month. A physical examination revealed marked hepatosplenomegaly without significant peripheral lymphadenopathies. Routine laboratory tests showed a hemoglobin level of 9.1 g/dL, 95 × 109/L platelets, 7.1 × 109/L leukocytes, and an elevated lactate dehydrogenase level of 522 U/L (reference interval, 120-220 U/L). A peripheral blood smear showed 2.0% atypical lymphoid cells with basophilic cytoplasm and multiple nucleoli (panel A). Bone marrow aspiration revealed 23.8% atypical lymphoid cells (panels B-C, arrows). The small cells had a scant cytoplasm and condensed chromatin, whereas the large cells had a voluminous cytoplasm and moderately dispersed chromatin. The accompanying dyshematopoiesis, including the megaloblastoid changes and pseudo-Pelger-Huët anomaly, was also recognized (arrow heads). Histological sections of the bone marrow showed the dendritic distribution of CD3+/CD4−/CD5−/CD7+/CD8−/CD56−/CD57−/GranzymeB−/TIA-1+/TCRβ−/TCRγ+-lymphoid cells, suggesting their sinusoidal infiltration (panel D, stained with anti-CD3). The patient was finally diagnosed with hepatosplenic T-cell lymphoma. / Hepatosplenic T-cell lymphoma is rare and is predominantly found in young male adults. Patients usually suffer from hepatosplenomegaly but not lymphadenopathy. The bone marrow is commonly involved, and peripheral blood infiltration becomes conspicuous in the clinical course. This disease usually shows an aggressive clinical course. No standard therapeutic strategy is currently established.

A previously healthy 23-year-old Japanese male had complained of a fever lasting a month. A physical examination revealed marked hepatosplenomegaly without significant peripheral lymphadenopathies. Routine laboratory tests showed a hemoglobin level of 9.1 g/dL, 95 × 109/L platelets, 7.1 × 109/L leukocytes, and an elevated lactate dehydrogenase level of 522 U/L (reference interval, 120-220 U/L). A peripheral blood smear showed 2.0% atypical lymphoid cells with basophilic cytoplasm and multiple nucleoli (panel A). Bone marrow aspiration revealed 23.8% atypical lymphoid cells (panels B-C, arrows). The small cells had a scant cytoplasm and condensed chromatin, whereas the large cells had a voluminous cytoplasm and moderately dispersed chromatin. The accompanying dyshematopoiesis, including the megaloblastoid changes and pseudo-Pelger-Huët anomaly, was also recognized (arrow heads). Histological sections of the bone marrow showed the dendritic distribution of CD3+/CD4−/CD5−/CD7+/CD8−/CD56−/CD57−/GranzymeB−/TIA-1+/TCRβ−/TCRγ+-lymphoid cells, suggesting their sinusoidal infiltration (panel D, stained with anti-CD3). The patient was finally diagnosed with hepatosplenic T-cell lymphoma.
Hepatosplenic T-cell lymphoma is rare and is predominantly found in young male adults. Patients usually suffer from hepatosplenomegaly but not lymphadenopathy. The bone marrow is commonly involved, and peripheral blood infiltration becomes conspicuous in the clinical course. This disease usually shows an aggressive clinical course. No standard therapeutic strategy is currently established.
A previously healthy 23-year-old Japanese male had complained of a fever lasting a month. A physical examination revealed marked hepatosplenomegaly without significant peripheral lymphadenopathies. Routine laboratory tests showed a hemoglobin level of 9.1 g/dL, 95 × 109/L platelets, 7.1 × 109/L leukocytes, and an elevated lactate dehydrogenase level of 522 U/L (reference interval, 120-220 U/L). A peripheral blood smear showed 2.0% atypical lymphoid cells with basophilic cytoplasm and multiple nucleoli (panel A). Bone marrow aspiration revealed 23.8% atypical lymphoid cells (panels B-C, arrows). The small cells had a scant cytoplasm and condensed chromatin, whereas the large cells had a voluminous cytoplasm and moderately dispersed chromatin. The accompanying dyshematopoiesis, including the megaloblastoid changes and pseudo-Pelger-Huët anomaly, was also recognized (arrow heads). Histological sections of the bone marrow showed the dendritic distribution of CD3+/CD4−/CD5−/CD7+/CD8−/CD56−/CD57−/GranzymeB−/TIA-1+/TCRβ−/TCRγ+-lymphoid cells, suggesting their sinusoidal infiltration (panel D, stained with anti-CD3). The patient was finally diagnosed with hepatosplenic T-cell lymphoma.
Hepatosplenic T-cell lymphoma is rare and is predominantly found in young male adults. Patients usually suffer from hepatosplenomegaly but not lymphadenopathy. The bone marrow is commonly involved, and peripheral blood infiltration becomes conspicuous in the clinical course. This disease usually shows an aggressive clinical course. No standard therapeutic strategy is currently established.
For additional images, visit the ASH IMAGE BANK, a reference and teaching tool that is continually updated with new atlas and case study images. For more information visit http://imagebank.hematology.org.
This feature is available to Subscribers Only
Sign In or Create an Account Close Modal